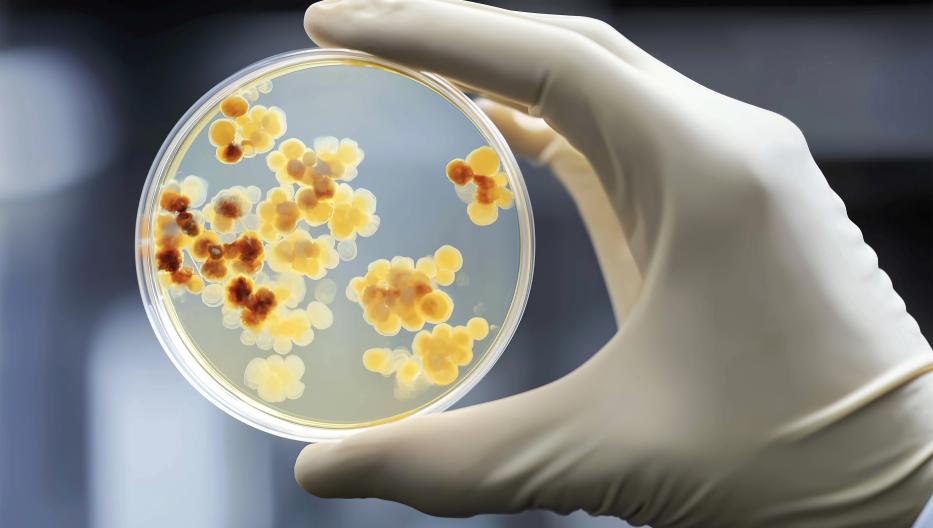

Infectiologie
Etablissement
Type de service
Consultation
Le service d’Infectiologie clinique accompagne des patients confrontés à des maladies infectieuses variées : infections cutanées, ostéo-articulaires, urinaires, tropicales, ou encore maladies sexuellement transmissibles, dont l’infection par le VIH.
Une prise en charge complète, au cœur de l’hôpital
Les activités du service s’articulent autour de plusieurs missions complémentaires :
- Un suivi en unité d’hospitalisation, dédiée aux patients nécessitant une surveillance rapprochée.
- Des avis spécialisés dans l’ensemble des services hospitaliers, pour soutenir les équipes dans les situations complexes.
- Des consultations spécifiques, permettant un diagnostic précis, un suivi de qualité et un accompagnement personnalisé.
Le service collabore étroitement avec le laboratoire de microbiologie, le service d’hygiène hospitalière ainsi que de nombreux autres départements, afin d’assurer une prise en charge cohérente et multidisciplinaire.
Des missions essentielles pour la santé de tous
Le service prend en charge :
- Les infections chez les patients immunodéprimés
- La gestion de l’usage des antibiotiques en milieu hospitalier (antibiogouvernance)
- Les actions de prévention : prophylaxie pré/post-exposition en cas de risque VIH, etc.
Quand demander un avis en Infectiologie ?
Certaines situations nécessitent l’évaluation d’un spécialiste, notamment :
- Fièvre persistante ou syndrome inflammatoire sans cause identifiée
- Suspicion de zoonose (borréliose, tularémie, babésiose, anaplasmose, etc.)
- Fièvre après un voyage ou suspicion de maladie tropicale
- Infections récidivantes (peau, tissus mous, infections urinaires…)
- Infections sexuellement transmissibles ou prise en charge VIH
- Accidents d’exposition au sang ou liquides biologiques
- Infections ostéo-articulaires ou endovasculaires
- Bilan d’adénopathie (en collaboration avec l’Hématologie)
- Conseils pour une antibiothérapie ciblée ou une dé-escalade thérapeutique